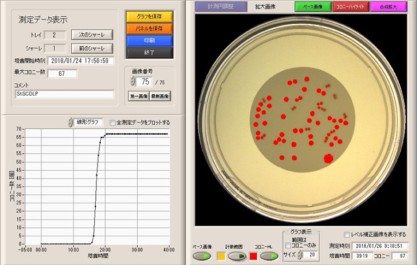

Rapid Sterility Test

For regenerative medicine, we provide sterility testing service, using Rapid Microbial Methods (microcolony method) performed in an isolator. Please feel free to contact us.
Features
- Rapid sterility testing can significantly shorten the measurement period compared with the sterility testing of the general tests, the Japanese Pharmacopoeia.
- We conform to the the Japan's Reliability Criteria *1, and GMP (Japan, USA, and Europe).
- This method specifically detects microorganisms that can proliferate in the presence of cells.
- The direct inoculation (surface-spread method on agar plates) and the membrane filtration method are applicable.
- *1: Article 43 of the Regulation for Enforcement of the Act on Securing Quality, Efficacy and Safety of Products Including Pharmaceuticals and Medical Devices
Details
- Measurement period: 2 days, which is 12 days shorter than 14 days of the sterility test of the general tests, the Japanese Pharmacopoeia.
- Rapid sterility test, where test results will promptly be available within 3 days after our receiving samples, in the earliest case.
- The following rapid sterility test was validated in our laboratory:
Microcolony method (using Microbio μ3D® manufactured by BD)
Six bacterial species directed in the Japanese Pharmacopoeia 17th Edition were detected.
Guideline referred; Parenteral Drug Association, Technical Report No. 33 (Revised 2013), EP 9th Chapter 5.1.6, USP40 <1223>, JP17 General Tests and Reference Information

Microbio μ3D® manufactured by BD
・Imaging colony shadows with CCD sensors
Test flow
Please inform us of test items and methods, and necessity of regulatory compliance depending on the purpose of the study. We will ask you the volume and transportation method of samples needed for the tests.
-
1.Preliminary testing to determine the applicability of test method, usually not under any regulations.
-
2.Validation of analytical procedures (Suitability of test methods, including confirmation of growth factors and inhibitors)
-
3.Quality Testing (Measurement of samples is conducted under GMP, if necessary.)
Example of quality testing timetable

- *1 Sample receipt and start of testing are available from Monday to Friday (excluding public holidays and closed days).
Our Experiences
Our Experiences of testing from FY2018
- Number of Clients: 7
- Number of studies: 60 or more, including 15 or more feasibility studies
Precautions regarding test samples
Please provide us with the following information in advance.
If samples should be handled under Biosafety level (BSL) 3 or higher or if the safety of samples cannot be ensured, we may not accept them.
- Information on infectivity of samples and pathogenic micro-organisms (origin, BSL, the methods that shows non-pathogenicity, status of inactivation, etc.)
- Whether β-lactam antibiotics are used or not
- Whether it is a genetically modified organism or not
Points to consider in providing samples derived from human cultured cells
When sending samples obtained from the human body to us, please review and get approval from your Ethical Review Committee, in accordance with the "Ethical Guidelines for Medical and Biological Research Involving Human Subjects", and take necessary measures required by this guideline.
Test facility
Contact Us for Services
